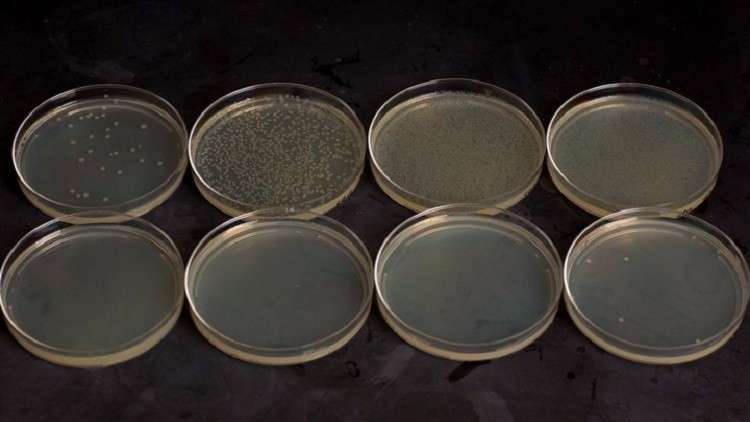

زرع العلماء في جينوم البكتيريا المحدثة آلية للتدمير الذاتي تشبه القنبلة الموقوتة، من أجل منع انتشارها في العالم.
وطوّر علم البيولوجيا الصناعية طرقا عديدة لتسخير الأحياء الدقيقة لخدمة الإنسان. وفي هذا المجال، تم تطوير البكتيريا لتصبح قادرة على معالجة البلاستيك، وتشخيص أمراض الأمعاء وعلاج السرطان وحتى إنتاج الأوكسيجين لمستعمري الكوكب الأحمر في المستقبل. بيد أن أحدا لا يعلم ما الذي سيحدث اذا خرجت هذه البكتيريا عن سيطرة الإنسان.
وقد تمكن فريق علمي من جامعة هارفرد برئاسة باميلا سيلفر من وضع منظومة من آليتين جزئيتين يزرعان في جينوم الأحياء الدقيقة، لتدميرها عند خروجها عن إطار “المنطقة المسموح بها”.
وتقوم الآلية الأولى بمنع الأحياء الدقيقة من إزالة وظيفة معينة في الجينوم خلال تطورها، وتضم الآلية جينا مسؤولا عن إفراز سم قاتل للبكتيريا، وما يسمى بـ”عنصر الذاكرة” الذي يميل لإنتاج مواد سامة.
أما الآلية الثانية فتعمل بنفس المبدأ، بيد أن حجب إنتاج المواد السامة يختفي عندما تنخفض درجة حرارة الوسط المحيط من 37 إلى 22 درجة مئوية. وهذا يعني أن بإمكان هذه البكتيريا البقاء على قيد الحياة فقط في جسم الكائنات الحية من ذوات الدم الحار. أي أن خروجها من هذه الأجسام يؤدي إلى موتها فورا.
كما أفادت باميلا سيلفر بأن العلماء تأكدوا، من خلال مراقبتهم ومتابعتهم لهذه الأحياء الدقيقة، من أن هذا الأمر ينتقل إلى 140 جيلا على أقل تقدير. ويعد هذا اختراق كبير يقربنا جدا من استخدام الأحياء الدقيقة المحدثة في جسم الإنسان والوسط المحيط.
المصدر: روسيا اليوم